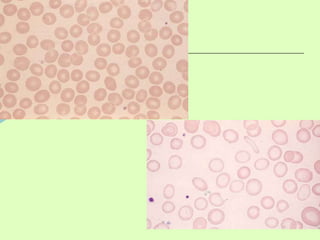

Thiếu máu thiếu sắt là vấn đề phổ biến ở Việt Nam, với 10-30% phụ nữ có thể bị ảnh hưởng. Các triệu chứng bao gồm mệt mỏi, đau đầu, và thấp IQ ở trẻ nhỏ; việc điều trị cần tập trung vào khôi phục các thông số hồng cầu và bổ sung sắt. Việc phân biệt giữa thiếu máu thiếu sắt và các bệnh như thalassemia rất quan trọng trong điều trị tối ưu.